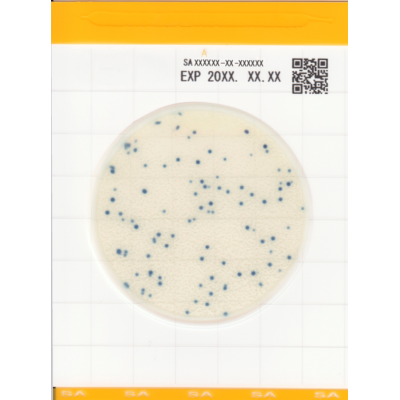
Easy Plate SA - Placi Teste Staphylococcus Aureus Rapide

Easy Plate SA - Placi Teste Staphylococcus Aureus Rapide
Transport Gratuit
Pentru comenzi peste 500 lei
Calitatea produselor garantata
Un nivel ridicat de calitate va determina o satisfacție mai deplină a clientului
Easy Plate SA este sistemul inovator de testare microbiologica destinat detectiei si numararii Staphylococcus aureus in produsele alimentare. Acest dispozitiv ready-to-use cu tripla certificare internationala (AOAC-PTM, NordVal, MicroVal) ofera precizie maxima, operare simplificata si eficienta superioara pentru laboratoarele moderne de siguranta alimentara.
Caracteristici Principale
Certificari si Standarde Internationale:
- Certificat AOAC PTM (SM 041302) - recunoscut la nivel mondial
- Validat NordVal si MicroVal pentru precizie maxima
Design Inovator si Functionalitate:
- Folie impermeabila cu mediu uscat preparat
- Capac transparent pentru monitorizare usoara
- Autodifuzant - proba se raspandeste automat pe supfata
- Nu necesita echipament specializat de laborator
- Gata de utilizare - fara preparare prealabila
- Protocol simplu in 3 pasi: extragere proba, pipetare, incubare
Metoda Easy Plate SA a primit certificarea SM (111703) de către Institutul de Cercetare AOAC pentru unsprezece matrici alimentare: carne de vită tocată crudă, miel crud, șuncă gătită, somon crud, creveți congelați, paste proaspete refrigerate, lapte pasteurizat, brânză naturală, foietaj cu smântână și salată de cartofi.
Specificatii Tehnice
| Produs | Easy Plate® SA |
| Producator | Easy Plate |
| Microorganisme tinta | Staphyloccocus aureus |
| Aplicatie | Testare probe carne, lapte, branza |
| Timp de incubare | 28 ore |
| Temperatura de incubare | 35 grade |
| Depozitare | 2-8 °C |
| Certificari | AOAC-PTM NordVal MicroVal |
| Continut pachet | 100 placi |
Set de produse